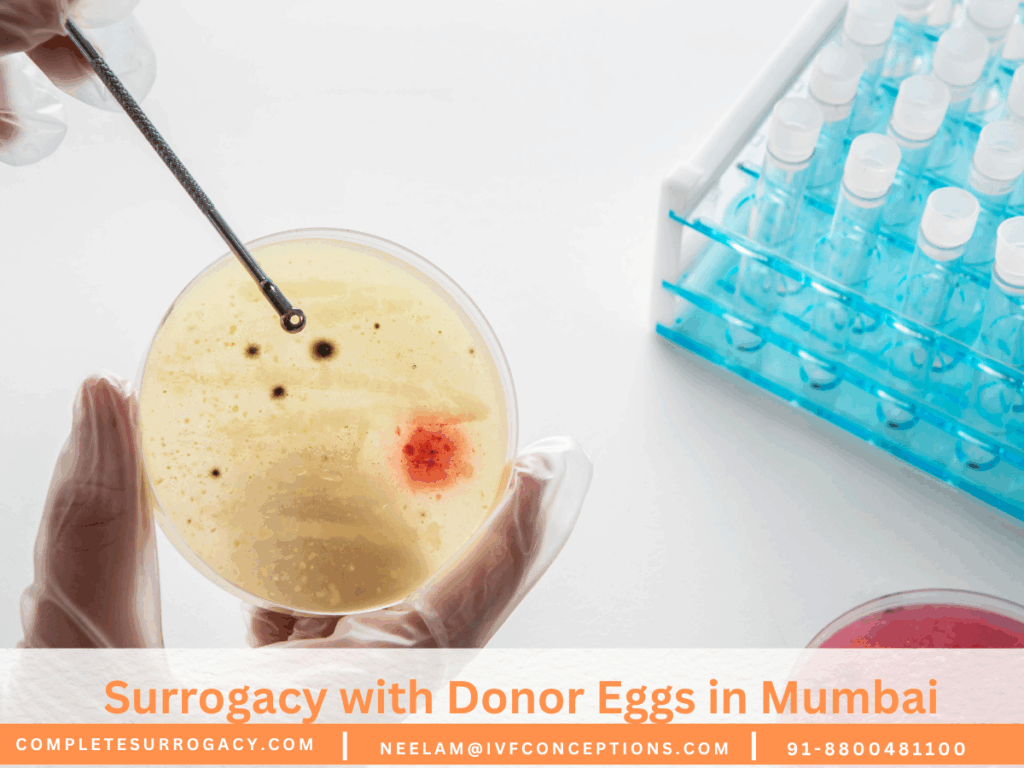
Surrogacy with Donor Eggs in Mumbai

Surrogacy Embryo Creation: The Essential Guide

Surrogacy embryo creation is the process of forming embryos through IVF using the intended parents’ or donors’ eggs and sperm before transfer to a gestational surrogate. It involves ovarian stimulation, egg retrieval, fertilization in a lab, and careful embryo development, often with optional genetic testing to improve success rates. Creating healthy embryos under strict medical […]
Egg Donor Selection Tips for Surrogacy and IVF.

Choosing the right donor is a crucial step, and following practical egg donor selection tips for surrogacy and IVF can greatly improve treatment outcomes. Intended parents should look beyond physical resemblance and focus on factors such as the donor’s age, medical and genetic history, fertility screening results, and prior donation success, as these directly impact […]
Finding a Surrogate Mother Abroad: A Step-by-Step Guide

Finding a surrogate mother abroad is an important step for intended parents seeking safe, legal, and reliable surrogacy options outside their home country. With varying laws and medical standards across nations, it’s essential to choose a destination that offers strong legal protections, transparent agency practices, and well-screened surrogates. This guide outlines what parents should look […]
Surrogacy with Donor Eggs in Mumbai: What You Should Know
Surrogacy with donor eggs in Mumbai is an increasingly popular option for intended parents facing fertility challenges such as poor egg quality, advanced maternal age, or genetic concerns. This treatment involves using eggs from a healthy donor, which are fertilized with sperm (from the intended father or a donor) and then transferred into a surrogate’s […]
Best Surrogacy Agencies in Mumbai: How to Choose the Right One

Finding the best surrogacy agencies in Mumbai is essential for ensuring a smooth, ethical, and legally compliant journey to parenthood. Mumbai is home to some of India’s most reputed fertility centers and surrogacy agencies, offering comprehensive support to both Indian and international intended parents. Whether you’re pursuing surrogacy with your own or donor eggs, a […]
How to Ship Embryos Internationally for Surrogacy Programs

Ever thought about how embryos can travel thousands of miles safely for surrogacy? Shipping embryos internationally is a complex task. It needs expert knowledge and careful planning. Shipping embryos across borders is key for families seeking surrogacy. This journey involves strict rules, special transport, and careful medical steps. These steps are to keep the embryos […]
Your Surrogacy Glossary: Key Terms Explained

Have you ever wondered how a few obscure words can hold the key to understanding the complex world of surrogacy? Whether you are being introduced to the idea for the first time or seeking deeper insight, this comprehensive surrogacy glossary will illuminate the essential vocabulary and definitions you need. Surrogacy can often feel overwhelming, loaded […]
Gestational Vs Traditional Surrogacy Explained

Gestational vs. Traditional Surrogacy Explained: Key Differences The main difference between gestational and traditional surrogacy lies in the genetic connection between the surrogate and the baby. In gestational surrogacy, the embryo is created using the intended parents’ or donor gametes through IVF, meaning the surrogate mother has no biological link to the child—she is solely […]
Types of Surrogacy: Understanding Gestational vs. Traditional Surrogacy

There are two main types of surrogacy arrangements – traditional and gestational. This article explains how each process works and key differences.
Gestational Surrogacy: A Definitive Guide

The surrogacy process is long and complex for almost all surrogacy journeys. Whether you’re an intended parent seeking to expand your family or a surrogate considering this selfless act, this guide will provide you with invaluable insights.

